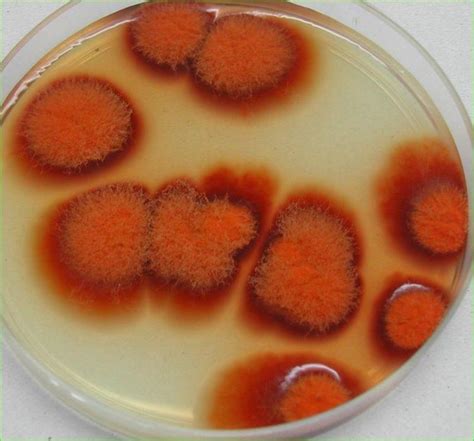
monascus purpureus curahan ilmu

Jika kamu sedang mencari Monascus Purpureus, maka anda berada di halaman yang tepat. Kami menyediakan aneka Monascus Purpureus yang bisa anda pesan online. Silakan hubungi kami via +6282245078486, jangan lupa sertakan juka gambar yang diinginkan.
Kami mengirim paket Monascus Purpureus melalui berbagai ekspedisi, misalnya JNE, JNT, POS, dll. Kami juga menerima pembayaran via BCA/Mandiri/dll. Pengiriman biasanya tidak sampai seminggu sudah sampai dan kami sertakan pula nomor resi yang bisa digunakan untuk tracking barang secara online.

Tidak hanya Monascus Purpureus, anda juga bisa melihat gambar lain seperti
Red Yeast Rice,
Under Microscope,
Gram Stain,
Burong Isda,
Homeopathic Medicine,
Fermented Tofu,
Red Yeast,
Went Logo,
Morphology Slides,
Pigment Production,
Lovastatin Atorvastatin,
and Yeast.
Berbagai Contoh Monascus Purpureus
Berikut kami sertakan berbagai contoh gambar untuk Monascus Purpureus, silakan save gambar di bawah dengan klik tombol pesan, anda akan kami arahkan pemesanan via WA ke +6282245078486.
 750×563
750×563
monascus purpureus alchetron social encyclopedia
Order Sekarang
 1255×1255
1255×1255
china monascus purpureus manufacturer supplier colorkem
Order Sekarang
 1019×1390
1019×1390
monascus purpureus res stock photography images alamy
Order Sekarang
 800×800
800×800
monascus purpureusmonascus purpureus extract powder tradekorea
Order Sekarang
 826×532
826×532
phylogeny monascus purpureus strains scientific diagram
Order Sekarang
 750×750
750×750
china monascus purpureus manufacturers suppliers factory good price
Order Sekarang
1317×1600
1317×1600
monascus purpureus species red yeast stock photo
Order Sekarang
 402×392
402×392
figura monascus purpureus colony rose bengal plate
Order Sekarang
 1300×956
1300×956
red yeast rice hongqu dried culture monascus purpureus stock
Order Sekarang
 800×800
800×800
monascus red natural food coloring powder red yeast rice extract
Order Sekarang
 504×607
504×607
growth performances monascus purpureus substrates
Order Sekarang
 479×479
479×479
production monascus purpureus nrrl pigments solid state
Order Sekarang
 640×640
640×640
effects saccharomyces cerevisiae mycelium biomass monascus
Order Sekarang
 740×620
740×620
enchanting pigment monascus red natures colorful secret
Order Sekarang
 850×422
850×422
production separation monascus purpureus nrrl pigments
Order Sekarang
 1070×636
1070×636
figure growth pigment production monascus purpureus
Order Sekarang
 400×400
400×400
monascus redmonascus red food color supplier factory nutriherb
Order Sekarang
Temukan solusi terbaik untuk kenyamanan ruang Anda dengan Monascus Purpureus! Produk peredam suara dan panas ini menawarkan performa maksimal dengan harga yang terjangkau. Dapatkan kualitas unggul tanpa menguras kantong, dan nikmati suasana tenang serta sejuk di setiap sudut rumah atau kantor Anda. Pilih Monascus Purpureus – pilihan cerdas untuk investasi jangka panjang!
Maaf, tidak ada yang cocok dengan kriteria yang Anda cari.
Apa yang ingin Anda lakukan?
« kembali ke Beranda atau gunakan kotak pencarian dibawah ini untuk mulai penelusuran baru.









